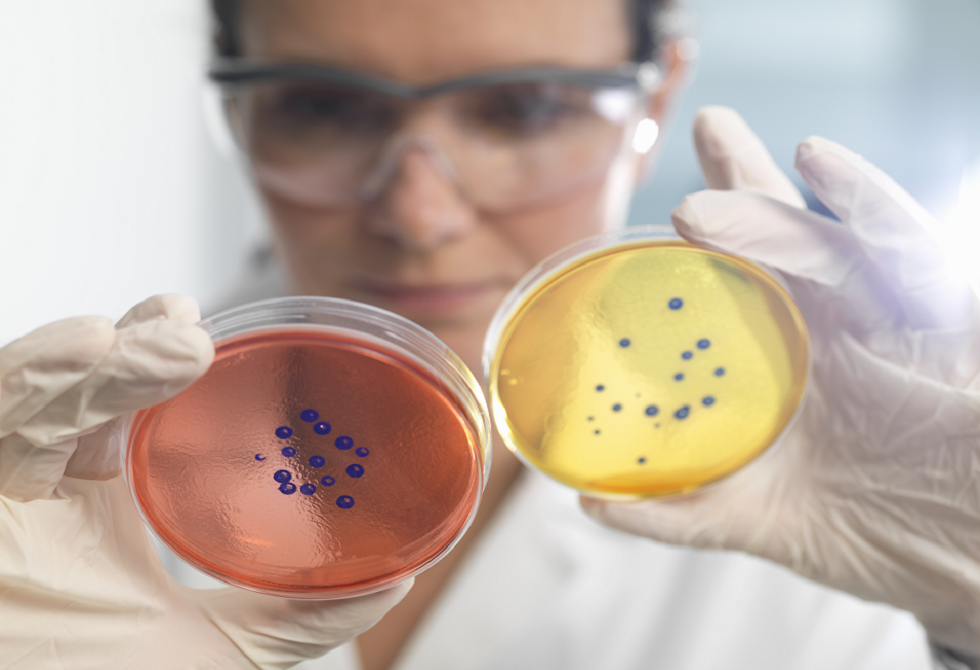

- «الحكم المحلي» تكثف جهودها لدعم البلديات
- ليبيا تشارك بتحقيقات سقوط «طائرة عسكرية» في تركيا
- الدبيبة يدعو لوقف «الصرف العشوائي» لإنهاء الأزمة: لم نقترض من البنوك
- 85 دولة تندد بسعي إسرائيل لـ"التوسع" في الضفة الغربية
- جيش أمريكا يعل قتل 11 شخصاً بغارات على 3 زوارق يُزعم أنها تهرب مخدرات
- "قالها 5 مرات".. مبابي يكشف تفاصيل واقعة "سب فينيسيوس"
- أين نقف الآن بعد محادثات أجرتها الوفود الأمريكية والإيرانية الثلاثاء؟
- "أجواء متوترة".. وويتكوف يؤكد مواصلة التفاوض بين كييف وموسكو
- سوريا:نساء علويات يروين لبي بي سي تفاصيل اختطافهن والاعتداء عليهن
- كيف أسهم شراء الأراضي والجزر في تكوين الولايات المتحدة بحدودها الحالية؟
- ميرتس مستاء من حفاوة استقبال روبيو.. "لو كنت حاضرا لما وقفت"
- موسكو تطالب "الناتو" بتوثيق "الوعد الشفهي" بعدم التوسع شرقا وإلغاء قرار بوخارست 2008
- "لا يوجد حل آخر".. سموتريتش: سندفع مجتمع العدو على الهجرة ونوسع الاستيطان
- إسرائيل تعلنها: سنشجع هجرة الفلسطينيين من الضفة وغزة
- بيع بطاقة "بوكيمون" نادرة مقابل أكثر من 16 مليون دولار
- ويتكوف: تقدم في المفاوضات بين وفدي روسيا وأوكرانيا
- مصر وسوريا والأردن وعدة دول تعلن الخميس أول شهر رمضان
- السعودية.. النيران تلتهم قصر باور (فيديو)
باحثون يربطون بين الكافيين وإبطاء شيخوخة الدماغ
يستمتع الناس في مختلف دول العالم بالقهوة والشاي، وتشير دراسة حديثة، إلى أن الاستهلاك المعتدل للقهوة والشاي قد يقلل من خطر الإصابة بالخرف ويبطئ التدهور المعرفي.
ويقول الدكتور نويد ستار، أخصائي طب القلب والأيض في جامعة غلاسكو: "هذه دراسة محكمة، بالنظر إلى نوع البيانات المتاحة. لأنها تعتمد على بيانات رصدية وليس تجريبية، ومع ذلك تعتبر النتائج التي حصل عليها الباحثون أولية".
وقد استخدم باحثون برئاسة نوه يو تشانغ، عالم الأوبئة في جامعة هارفارد في كامبريدج، بيانات من دراستين صحيتين طويلتي الأمد - دراسة صحة الممرضات ودراسة متابعة العاملين في المجال الصحي - لتتبع عادات استهلاك الكافيين لأكثر من 130 ألف عامل في المجال الصحي على مدى 43 عاما. وقد ملء المشاركون استبيانات حول نظامهم الغذائي وقدراتهم المعرفية.
وأظهرت النتائج أن الاستهلاك المعتدل للكافيين (2-3 أكواب من القهوة أو 1-2 كوب من الشاي يوميا) يرتبط بأكبر انخفاض بخطر الإصابة بالخرف وإبطاء التدهور المعرفي. وحتى أدنى مستوى من الاستهلاك أظهر تأثيرا إيجابيا على الدماغ.
ويؤكد الباحثون أن العلاقة بين استهلاك الكافيين والصحة المعرفية استمرت حتى بين المشاركين الذين يشربون كميات كبيرة من القهوة - تصل إلى خمسة أكواب يوميا. كان خطر إصابة هؤلاء الأشخاص بالخرف أقل بنسبة 18 بالمئة مقارنة بمن يشربون كميات أقل من القهوة أو لا يشربونها على الإطلاق.
ووفقا للباحثين، مع أن الدراسة لا تؤكد بشكل مباشر أن استهلاك القهوة يقلل من خطر الإصابة بالخرف، إلا أن البيانات تكشف الدور المهم للكافيين في تحسين الوظائف المعرفية. وقد يكون هذا أحد مكونات نهج شامل لحماية الدماغ من آثار الشيخوخة.
ويقول نو يو تشانغ: "حجم التأثير صغير، وهناك العديد من الطرق المهمة لحماية الوظائف المعرفية في الشيخوخة. وتشير دراستنا إلى أن شرب القهوة أو الشاي المحتوي على الكافيين قد يكون جزءا من حل هذه المشكلة".
المصدر: صحيفة "إزفيستيا"
 المصدر:
روسيا اليوم
المصدر:
روسيا اليوم